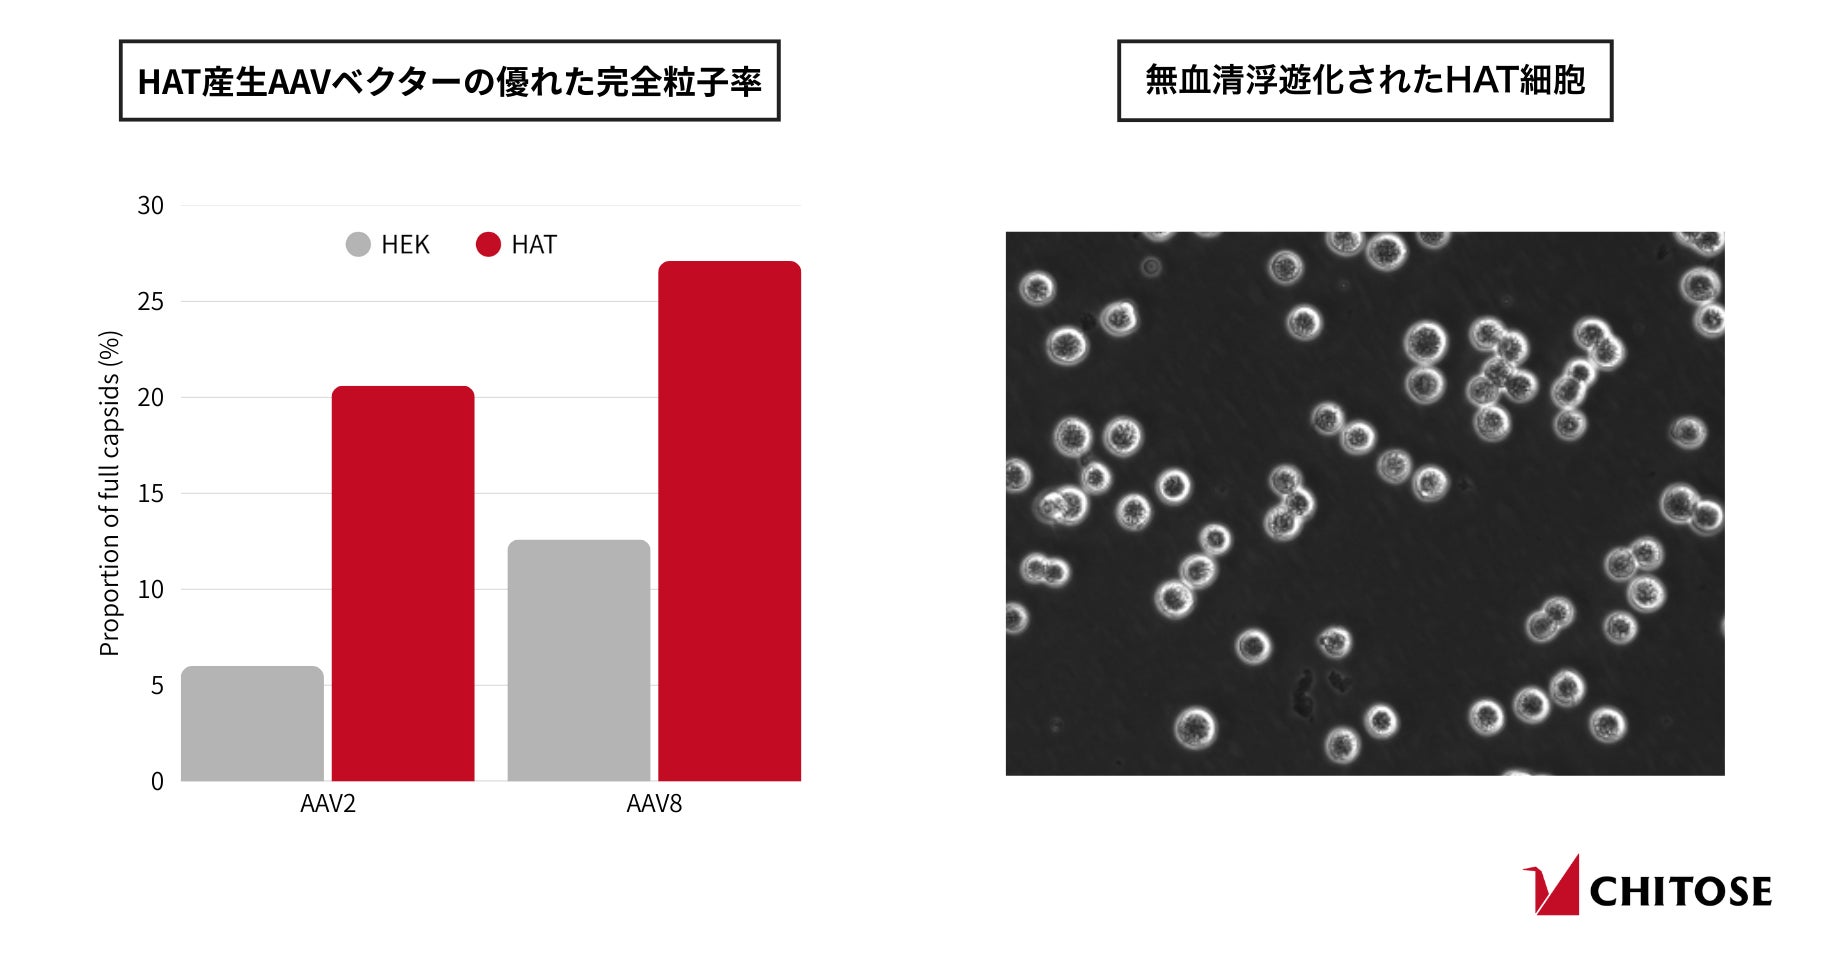

遺伝子治療用ウイルスベクター生産用宿主細胞として新たに開発されたHAT細胞が『Molecular Therapy Methods & Clinical Development』誌に掲載、商用提供開始
ちとせグループの中核法人である株式会社ちとせ研究所(以下、ちとせ)は、2022年に樹立した遺伝子・細胞治療用ヒト羊膜上皮由来細胞株(以下、HAT細胞)の商用提供を開始いたしました。HAT細胞は、従来の細胞株と比較してアデノ随伴ウイルス(以下、AAV)ベクターの生産収量および品質を向上させることで、バイオ医薬品製造コストの削減と遺伝子治療の普及拡大に貢献する可能性を有しています。本成果は、遺伝子治療分野で高い影響力を持つ査読付き国際学術誌に掲載され、その科学的妥当性が国際的に評価されました。
高生産性バイオ医薬品製造で、遺伝子治療へのアクセスを拡大
非病原性ウイルスに由来するAAVベクターを用いた遺伝子治療は、遺伝子を効率的に送達する能力により、これまで治療が困難とされていた疾患に対する新たな治療法として注目されています。一方で、AAVベクターの大規模生産や精製、品質管理には依然として課題が多く、遺伝子治療薬が極めて高額になることが普及の妨げになっています。そのため、遺伝子治療用AAVベクターの製造効率向上は、遺伝子治療を必要とする人々が適切な治療へアクセスできるようになるうえで、極めて重要な鍵となります。
HAT細胞の特長
ヒト由来羊膜細胞より新たに樹立されたHAT細胞は、AAVベクターを高効率・高収量で、かつ不純物が少ない状態で生産できることから、製造コストの削減に貢献します。なお、HAT細胞の樹立過程や特性の詳細については、遺伝子治療分野で高い権威を有す査読付き専門誌『Molecular Therapy Methods & Clinical Development』に掲載されています※1。
HAT細胞の主な特長は以下の通りです。
● 高い生産性:
選抜トップHAT細胞は、幅広い血清型のAAVベクターに対して高い生産性を示し、AAV5では培養液1リットルあたり2.7 × 10¹⁴vg(ベクターゲノム)という高い生産性を達成した。
● 産生ベクター品質の向上:
HAT細胞で産生されたAAVベクターは、HEK293細胞と比較して高い完全粒子の割合を示した(AAV2:20.6%対6.0%、AAV8:27.1%対12.6%)。
● 生産スケーラビリティ:
3リットルのベンチトップ型バイオリアクターを用いた生産培養試験においても、AAVベクターの収量・品質は維持され高い規模拡張性を示した。
● 倫理的な起源:
商用利用を含む目的で取得されたとしたインフォームド・コンセントに基づいて提供された組織を起源として樹立された。
本開発は、目的の性能を備えた細胞の培養・選抜を可能にするちとせの独自技術によって実現しました。この技術は、抗体医薬品製造用に設計され既に商用化されている高生産性宿主細胞株「CHO-MK」※2の開発にも活用されています。ちとせは、CHO-MK細胞およびHAT細胞の新規樹立を通じて、バイオ医薬品産業の発展と、命を救う次世代治療へのアクセス向上に貢献していきます。
※1 Establishment of a novel human amniotic epithelial-derived cell line, HAT, for high-yield AAV vector production
Hirai, Yugo et al. Molecular Therapy Methods & Clinical Development, Volume 33, Issue 4, 101594
※2 CHO-MK細胞はAMEDの支援のもと樹立されました(助成番号 JP18ae0101054)。
研究開発および協力体制
本開発は、ちとせおよび次世代バイオ医薬品製造技術研究組合(以下、MAB組合)が主体となり、国立成育医療研究センター協力のもと実施しました※3。また国立研究開発法人日本医療研究開発機構(AMED)の以下の事業による支援を受けています。
再生医療・遺伝子治療の産業化に向けた基盤技術開発事業(遺伝子治療製造技術開発)
課題名:遺伝子・細胞治療用ベクターのプラットフォーム製造技術開発(JP18ae0201001)
研究開発代表者:大政 健史
再生医療・遺伝子治療の産業化に向けた基盤技術開発事業(遺伝子治療開発加速化研究事業)
課題名:ウイルスベクター製造技術の統合開発(JP24se0123004)
研究開発代表者:大政 健史
※3 ちとせと国立成育医療研究センターは、MABの組合員です。
提供および問い合わせ
ちとせは、HAT A2C1細胞の商用利用においてMAB組合に認定された唯一の事業者です。HAT A2C1細胞の入手に関するお問い合わせや詳細については、以下メールアドレスまでご連絡ください。

<ちとせグループ概要>

ちとせグループは、世界のバイオエコノミーをリードするバイオ企業群です。千年先まで人類が豊かに暮らせる環境を残すべく、国や多くの企業と協力し、経済合理性を成立させながら技術を社会に展開しています。
◯ちとせグループ全体を統括する「CHITOSE BIO EVOLUTION PTE. LTD.」の概要
・設立:2011年10月
・本社:シンガポール
・代表者:CEO 藤田朋宏 Ph.D.
◯ちとせグループの中核法人として、技術開発・事業開発を行う「株式会社ちとせ研究所」の概要
・設立:2002年11月
・本社:神奈川県川崎市
・代表者:代表取締役CEO 藤田朋宏 Ph.D./代表取締役COO 釘宮理恵
このプレスリリースには、メディア関係者向けの情報があります
メディアユーザー登録を行うと、企業担当者の連絡先や、イベント・記者会見の情報など様々な特記情報を閲覧できます。※内容はプレスリリースにより異なります。
すべての画像
